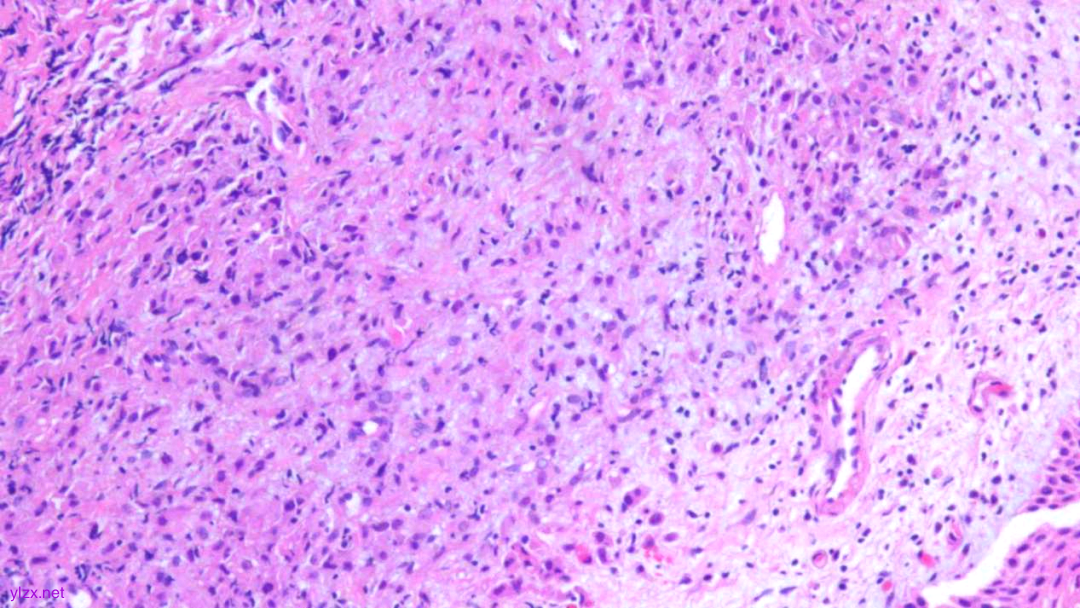
图片
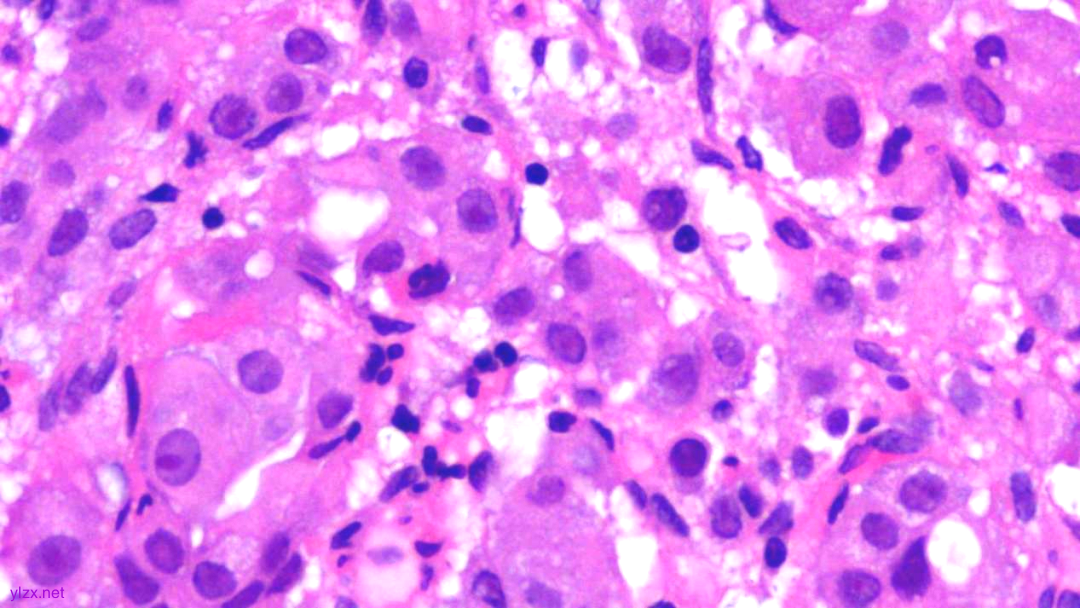
图片
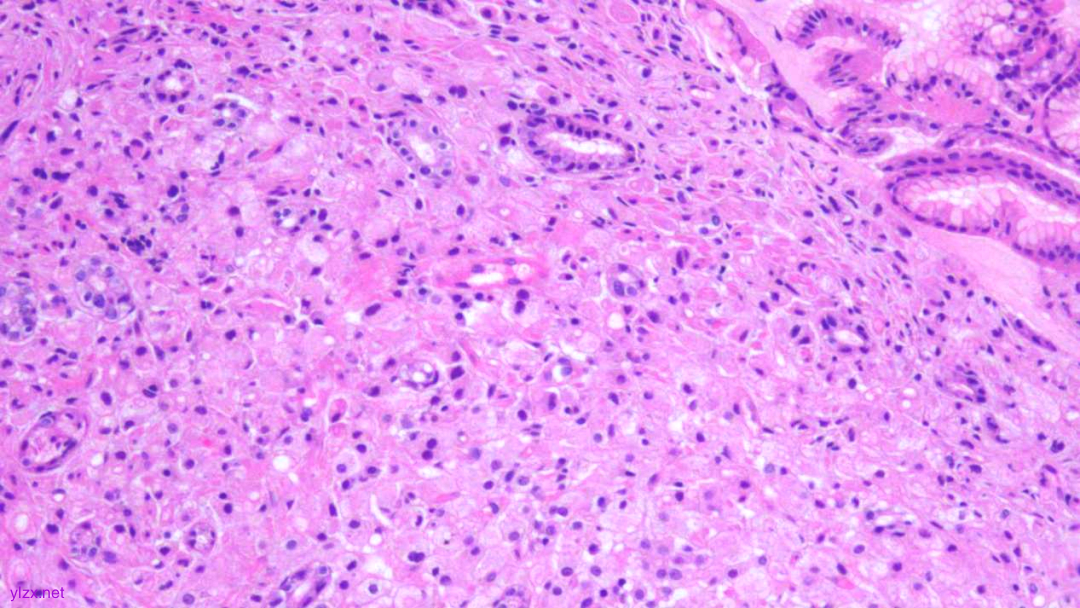
图片
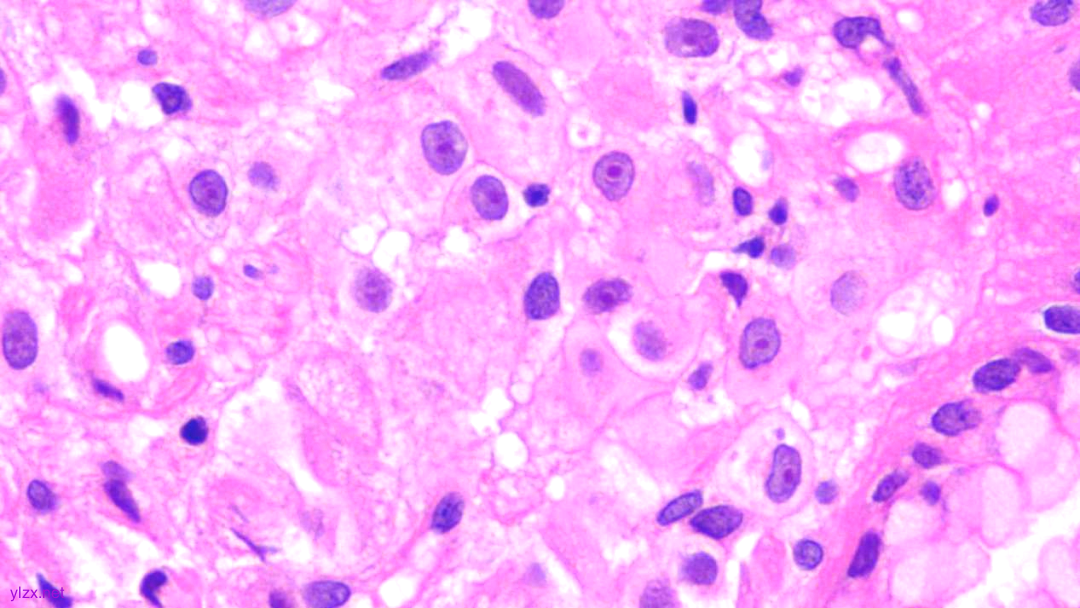
图片

基础病例 | 乳腺浸润性小叶癌伴多发转移一例
时间:2025-04-10 12:17:34 热度:37.1℃ 作者:网络
病史:
患者,女,46岁,2024年3月因接触性出血来我院妇科就诊。
实验室检查:
CA125、CA199、CEA均升高。
妇科检查:
1.外阴良好,阴道通畅;
2.宫颈略大,黏膜充血、质地硬、宫口闭,触血阳性;
3.子宫占位,活动可,无压痛;
4.右侧附件区可触及包块,无压痛;
5.左侧附件区未见异常。
上下腹部+胸部+盆腔CT增强示:
左乳腺癌术后,乳房缺如,术区未见明确异常强化;
其余:
1.胃小弯异常强化灶;
2.腹膜后、双侧髂血管旁、双侧腹股沟多发肿大淋巴结;
3.腹壁皮下结节;
4.子宫及右侧卵巢见肿物;
5.腹膜、肠系膜、网膜上见结节;
6.腹盆腔少量积液。
PET-CT检查:
1.甲状腺癌术后改变,双侧颈部多发淋巴结,部分FDG代谢稍高,淋巴结较前增多、增大,不除外转移;
2.胃窦部胃壁增厚;
3.子宫占位,考虑恶性肿瘤,右盆腔转移瘤。
病理检查:
一.宫颈多点活检、宫颈管搔刮组织:
大体:
宫颈2点、5点、10点:灰白组织1---2粒,0.5cm;
宫颈管搔刮组织:暗红色组织,约0.8cm,均全取。
镜下:
HE:
1.宫颈2点、10点:鳞状上皮下间质内见瘤组织弥漫增生,胞浆宽阔,红染,核小,较一致,部分细胞核偏位,部分细胞可见核仁;
2.宫颈5点:鳞状上皮下间质内见少量异型细胞巢,核增大,深染,浆红染,少量细胞浆内见黏液,印戒样;宫颈管搔刮组织:见血凝块、宫颈内膜组织,间质见异型细胞条索,形态同宫颈5点。

鳞状上皮下间质内见瘤组织弥漫增生,胞浆宽阔、红染,核小,较一致
瘤细胞排列偏稀疏,核小,深染,胞浆红

间质内见异型细胞巢,核增大,深染

间质内见异型细胞条索,核增大,深染,浆红

少量细胞浆内见黏液,印戒样

瘤细胞核偏位,浆红染
高倍瘤细胞见红色核仁
IHC结果:
P120(浆+),P16(灶+),P53(野生型表达),Her2(1+),CK7、GATA3、GCDFP-15、CK-H均(+),ER、PR、E-Cadherin、CK20均(-),Ki67(约5%+)

ER(-)

PR(-)

P120(+)

P120(部分+)

E-Cadherin(-)

GCDFP-15(弥漫+)

GATA-3(+)

CK7(弥漫强+)

Her2(1+)

Ki-67(散在+)
病理诊断:
(宫颈2点、5点、10点活检组织及宫颈管搔刮组织)HE形态结合临床病史、免疫组化结果,符合乳腺浸润性小叶癌转移。
二.胃窦黏膜活检:
大体:
活检组织4块,约0.4cm,全取。
镜下:
HE:
黏膜间质内见胞浆丰富,红染及粉染瘤细胞弥漫分布,部分细胞核稍偏位,核圆形,稍增大,深染,见核仁,穿插在固有腺之间,伴少量炎细胞浸润。

瘤组织穿插在固有腺之间,较弥漫,核稍增大,深染
瘤细胞稀疏排列,胞浆粉染及红染,宽阔

瘤细胞核圆形,见核仁,部分细胞核偏位,未见核分裂象
瘤细胞核仁明显
IHC结果:
CK(AE1/AE3)(+)、GATA3(+)、P120(浆+)、E-Cadherin(-)、CK7(+)、CK-H(+)、CAM5.2(+)、CK20(-)、CEA(poly)(-),P53(约40% 弱+),Ki-67(约1%+)

AE1/AE3(弥漫强+)

GATA-3(+)

P120(浆+)

E-Cadherin(-)

CEA(少量+)

CK7(弥漫强+)

ki-67(个别细胞+)
病理诊断:
(胃窦)腺癌,HE形态结合临床病史、免疫组化结果,符合乳腺浸润性小叶癌转移。
讨 论
乳腺癌发病率呈逐年上升趋势,严重危害人类健康,乳腺癌转移是影响患者预后的一个重要因素,尤其是部分患者在早期便发生了远处转移,癌细胞可经淋巴循环进入静脉,也可直接进入血液循环系统,发生了远处转移。
乳腺浸润性小叶癌(Invasive Lobular Carcinoma,ILC)是浸润性癌中第二种常见类型,占乳腺癌10-15%,组织学表现为失黏附的细胞散在、单排、线状排列,经典型预后好,一般患者年龄更大。
最新研究表明,85%ILC具有CDH1突变,E-Ca蛋白异常表达有:膜染色强度低,部分或点状膜表达,胞质异常染色,甚至强膜染色,注意不要误诊。56%存在CDH1启动子甲基化,AXIN2基因功能缺失可能是导致缺乏CDH1突变原因,故联合AXIN2抗体进行免疫组化检测,可更好的筛选ILC。
ILC的转移有别于浸润性导管癌,常转移至:骨、胃肠道、子宫、脑膜、卵巢和浆膜等部位,而浸润性导管癌多发生肺转移。
一.ILC发生女性生殖系统转移:
间隔时间通常为5-20年,最常见的转移部位是卵巢,其次是输卵管,最后是子宫,相比宫颈转移较为罕见,这可能是因为宫颈体积小,纤维肌层厚,且血液供应有限。
阴道异常出血可能是ILC转移至子宫的临床表现,但也有病例,尽管发生了宫颈和双附件转移,但未出现出血及特异性妇科症状,是在TCT及乳腺癌术后的常规复查中被发现的。
二.ILC发生胃肠道转移:
初次诊断ILC到转移时间间隔通常较长,平均7年,罕见,一些患者在因消化道症状就诊时可能会忘记提及自己的乳腺癌病史,小叶癌发生胃肠道转移的发生率仅为4.5%。
最常见的部位是胃,其次是小肠,最后是结肠。
临床表现缺乏特异性,常表现为消化不良、食欲不振、发热、恶心、 呕吐、胃出血、上腹痛等症状。
胃镜检查常见是皮革胃,也可表现为息肉样肿块、溃疡,单发转移较多发转移更为常见,多数表浅,多为黏膜下病变。活检存在的问题是如果取样太表浅,则无法发现癌细胞,故胃镜需要进行广泛的深层组织取样。
结直肠转移最常见症状是排便习惯改变,其次为肠梗阻、腹痛和腹胀,可能被误诊为原发性肿瘤,需要进行免疫组化确诊。
三.ILC发生腹膜转移及皮肤转移:
在腹膜表面形成多个突起小结节,与卵巢癌相似。
皮肤转移乳腺癌一般在真皮及皮下组织内,少累及表皮及皮肤附属器,浸润性导管癌多见,其次为ILC,前胸壁,同侧多见,单灶-多灶均可。
四.原发及ILC转移癌鉴别诊断:
1.转移灶通常与原发部位有相同组织学特征和分子分型:
表达乳腺来源的标记物,如GATA-3,GCDFP-15和Mammaglobin;
在分子分型上,肿瘤细胞通常为ER阳性、Her2阴性。
2.在少数情况下,转移部位的分子分型可能与原发灶不同:
转移灶分子分型为三阴性,最常见的变化是激素受体状态从阳性转变为阴性,治疗策略也需要相应调整。
3.低黏附性癌的女性患者:
常规询问病史,加做免疫组化,如GATA-3、AR等标志物,胃原发的低黏附性癌常表现为印戒细胞,而转移性ILC,女性生殖原发腺癌极为罕见。
胃原发灶常伴随表面小凹和固有腺体出现高级别上皮内瘤变及腺体破坏,而转移癌形态相对温和,常见核偏移,胞质呈粉红色或透明,更易在腺体间隙中移动,较少破坏固有腺体;E-Ca表达缺失以及P120阳性,E-Ca缺失可解释ILC倾向于转移到一些少见的远端部位。
治疗及预后:
如出现穿孔、出血或肠梗阻,手术切除转移瘤进行全身治疗,避免误诊为原发肿瘤而造成过度扩大切除。
ILC转移到胃肠道5年生存率为29%,至女性生殖系统的患者中位生存期为1.6年,腹膜转移的患者,治疗限于化疗或激素治疗。
诊断经过:
本例发生了宫颈、胃窦转移,追踪了患者既往病史(2019.12-2025.1,5年余期间),如下:
2019-12-22:
在中山大学附属第七医院体检:甲状腺左、右侧叶均见结节。
2019-12-27:
行甲状腺全切+双侧中央区淋巴结清扫术+术中喉返神经探查监测术,术后病理:(左、右侧叶)甲状腺乳头状癌,术后恢复良好,口服甲状腺素片。
2021-3-19:
左乳内上象限距乳晕边缘约0.5cm处可触及1×1cm肿物,质硬,界欠清。左乳彩超示:见肿物BI-RADS 4A,穿刺活检,病理结果:(左乳)乳腺浸润性癌(病理号为TA02062),免疫组组化结果:ER(95%+)、PR(-)、Her-2(1+)、P120(浆+)、E-ca(-)、CK5/6(-)、P53(-)、Ki67(5%+),Calponin、CK5/6、P63显示浸润性癌周围肌上皮细胞缺失,原位癌导管周围肌上皮存在。
2021-3-26:
入院完善相关检查,全麻下行左侧乳腺癌改良根治术+左侧腋窝淋巴结清扫术+左侧副乳腺切除术。术后病理:1.(左乳)乳腺浸润性小叶癌,大小范围约为8X7mm,并见较多小叶原位癌及散在的浸润性小叶癌灶,II级,Nottingham评分:腺管形成3分,细胞多形性2分,病理性核分裂象1分,3+2+1=6分,神经未见癌侵犯,脉管内见癌栓。免疫组化结果:ER(约80%强+)、PR(-)、Her-2(1+)、CK5/6(-)、E-Cad(-)、P120浆(+)、P63(-)、P53(-)、EGFR(-)、Ki67(约8%+)。2.送检(上、下、外及基底切缘)均见小叶原位癌,(内切缘)未见癌组织。
2021-4至9:
制定化疗方案“AC-T”方案化疗8周期,并规范进行放疗及内分泌治疗。
2024-3-7:
出现接触性出血来我院妇科检查。
2025-1-26:
腹水增多1月余,感腹胀、胸闷、气促、呼吸困难。腹水细胞涂片:见癌细胞。

诊断体会:
1.本例发生了宫颈及胃窦转移,患者并无消化道症状,仅行常规胃镜检查取活检。
2.本例IHC是从原发ILC的激素依赖型到转移灶三阴性。
3.根据患者的影像检查结果,ILC发生多发远处转移,但只活检了宫颈及胃窦,并未切除卵巢等其他部位转移灶,故未能看到病变全貌。
4.本例为自己在实践工作中遇见的典型病例,对相关知识进行及时梳理、回顾分析、总结复习及拓展思维,不断提高诊断水平。
*本文(包括图片)均为作者投稿, 仅供行业交流学习用,不作为医疗诊断依据。
参考文献
1.刘月平.乳腺癌组织病理诊断的几个热点问题[J].临床与实验病理学杂志,2023(08):897-900.doi:10.13315/j.cnki.cjcep.2023.08.001
2.管枫,罗斌,柯晓康等.少见部位转移性乳腺浸润性小叶癌临床病理特征分析[ J/CD].中华乳腺病杂志( 电子版), 2024,18(3):169-174.
3.《乳腺组织病理学图谱》下册,主编:丁华野,审订:丁彦青,北京科学技术出版社。

